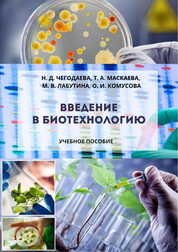

Биотехнология Подписаться Обратная связь Новые поступления в библиотеку
Новые поступления за февраль 2026 года
Генетические технологии и медицина: доктрина, законодательство, практика. Монография
Мохов А. А. и др.
2021 год
2021 год
Генетические технологии и право в период становления биоэкономики. Монография
Мохов А. А. и др.
2020 год
2020 год
Новые поступления за январь 2026 года
Список литературы пока пуст.
Новые поступления за декабрь 2025 года
Список литературы пока пуст.
Новые поступления за ноябрь 2025 года
Список литературы пока пуст.
Новые поступления за октябрь 2025 года
Список литературы пока пуст.
Новые поступления за сентябрь 2025 года
Список литературы пока пуст.
Последнее изменение 01.03.2026